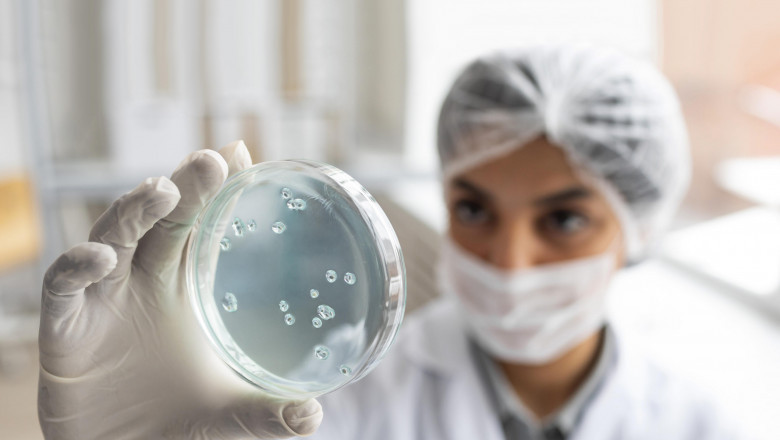

views
The integrity of a tissue sample is examined during tissue diagnostics. This method can detect cancer cells or malignant tissues in some circumstances. This approach is also used in the diagnosis of cancer in diagnostic laboratories. Tissue diagnostics are usually done on slides and are automated. Instrument reagent and staining reagent systems are examples of these systems. The tissue diagnosis procedure is both quick and accurate.
The process of tissue diagnostic can be challenging, and it frequently necessitates the assistance of a specialist. A physician must be an expert in the field to ensure reliable results. A pathologist must perform a direct visual and tactile inspection and report the results. The biopsy is then sent to a laboratory for testing. The treatment can be completed right away in some circumstances, but the tissue must be processed overnight in others. The tissue must be referred to a pathology facility for accurate interpretation.
Read more @https://latesthighlightscmi.blogspot.com/2021/12/tissue-diagnostic-methods-continue-to.html